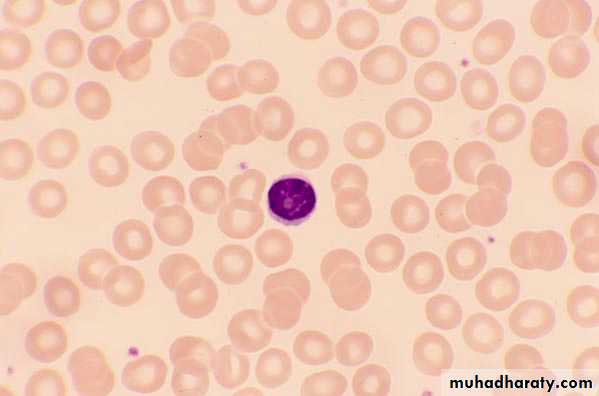
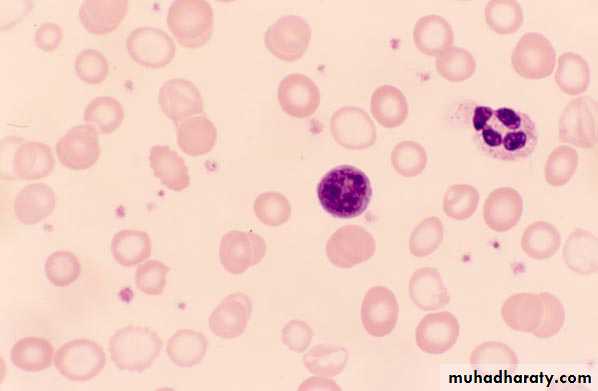

PEDIATRIC HEMATOLOGY
ByDr. ESSAM AHMED
M.B.Ch.B, F.I.B.M.S
Peadiatric Hemato-Oncologist
Objectives
1- to understand the definition of anemia and recognize its different types according to their etiology2- to be able to approaches to patient with anemia (investigations and treatment)
3- to be able to approaches to patients with bleeding tendency4- to know the commonest malignancy in pediatrics (Leukemia) and to know the important steps in its diagnosis and treatment
Anemia
can be defined as a reduction in hemoglobin concentration, hematocrit (packed cell volume) or number of red blood cells per cubic millimeter(for age and sex)
• Etiologic Classification of Anemia in Children
• I. Impaired red cell formation• A. Deficiency:e.g Iron deficiency, Folate deficiency, Vitamin B12 deficiency
• B. Bone marrow failure
• II. Hemolytic anemia
• A. Corpuscular
• 1. Membrane defects (spherocytosis,elliptocytosis)
• 2. Enzymatic defects (G6PD)
• 3. Hemoglobin defects
• a. Heme
• b. Globin (1) Qualitative (e.g., sickle cell)
• (2) Quantitative (e.g., thalassemia)
• B. Extracorpuscular
• 1. Immune:
• a. Isoimmune
• b. Autoimmune
• 2. Nonimmune (idiopathic, secondary)
• III. Blood loss
The blood smear(blood film) is very helpful in the diagnosis of anemia.
It establishes whether the anemia ishypochromic, microcytic,
normocytic,
macrocytic
or shows specific morphologic abnormalities suggestive of red cell membrane disorders (e.g., spherocytes, stomatocytosis or elliptocytosis) or hemoglobinopathies (e.g. sickle cell disease).
The reticulocyte count are helpful in the differential diagnosis of anemia. An elevated reticulocyte count suggests blood loss or hemolysis;
while normal or depressed count suggests impaired red cell formation.
The reticulocyte count must be adjusted for the level of anemia to obtain the reticulocyte index,* (a more accurate reflection of erythropoiesis).
*Reticulocyte index=reticulocyte countXpatient’s hematocrit/normal hematocrit. Example: reticulocyte count6%, hematocrit 15%, reticulocyte index=6X15/45=2%.
bone marrow examination
• In more refractory cases of anemia, may be indicated
• to
• -estimate iron stores
• -diagnose the presence of a normoblastic, megaloblastic, or sideroblastic morphology.
• Iron-Deficiency Anemia
is the most common hematologic disease of infancy. It is estimated that 40-50% of children under 5 years of age in developing countries are iron-deficient .• Peak prevalence occurs during late infancy and early childhood when the following may occur:
• • Rapid growth
• • Low levels of dietary iron
• • Complicating effect of cow’s milk-induced enteropathy due to whole cow’s milk ingestion
• A second peak is seen during adolescence due to rapid growth and suboptimal iron intake. This is amplified in females due to menstrual blood loss.
• The body of a newborn infant contains about 0.5 g of iron, adult content 5 g.
• So 0.8-1 mg of iron must be absorbed each day during the first 15 yr of life to reach the adult level.• In addition to this growth requirement, a small amount is necessary to balance normal losses of iron by shedding of cells.
• Absorption of dietary iron is assumed to be about 10%; So a diet containing 8–10 mg of iron daily is necessary for optimal nutrition. Iron is absorbed in the proximal small intestine.
• ETIOLOGIC FACTORS
• Diet• A newborn infant is fed predominantly on milk.
• Breast milk and cow’s milk contain (0.5–1.5 mg/L).
• Breast-fed infants absorb 49% of the iron, in contrast to about 10% absorbed from cow’s milk.
• Formulas with 7–12 mg Fe/L for full-term infants and premature infant formulas with 15 mg/L for infants <1,800 g at birth are effective.
• Iron Content of Infant Foods
• Food Iron(mg)
• Milk 0.5–1.5 /liter
• Eggs 1.2 each
• Cereal(fortified ) 3.0–5.0 ounce
• Vegetables
• Yellow 0.1–0.3 ounce
• Green 0.3–0.4 ounce
• Fruits 0.2–0.4 ounce
• Meats
• Beef, lamb 0.4–2.0 ounce
• liver 6.6 ounce
• Growth
• Growth is particularly rapid during infancy and during puberty. Each kilogram gain in weight requires an increase of(35–45 mg) body iron.
• -Stores usually are sufficient for blood formation in the first
• 6–9 months of life in term infants and by 3–4 months in a premature infant.
• Delayed clamping of the umbilical cord (∼2 min) in developing countries may reduce the incidence of iron deficiency.
• Blood Loss
• Blood loss must be considered as a possible cause in every case of iron-deficiency anemia, particularly in older children.• Hemorrhage may be either occult or apparent.
- Lesion of the gstrointestinal tract
• Milk protein–induced inflammatory colitis
• Peptic ulcer
• Meckel diverticulum
• Polyp, or hemangioma
• Inflammatory bowel disease
• Hookworm infestation
• - Pulmonary hemosiderosis
• Impaired Absorption
• Impaired iron absorption due to a generalized malabsorption syndrome is an uncommon cause of iron-deficiency anemia.
• CLINICAL MANIFESTATIONS
*Pallor( palmar pallor) is the most important sign of iron deficiency.
*Pagophagia(pica), the desire to ingest unusual substances such as ice or dirt, may be present. In some children, ingestion of lead-containing substances may lead to concomitant plumbism (chronic lead poisoning)
• *When the hemoglobin level falls to <5 g/dL,
• irritability• anorexia
• Tachycardia, cardiac dilation , and systolic murmurs are often present.
• *Children with iron-deficiency anemia may be obese or may be underweight.
• *Iron deficiency may have effects on neurologic and intellectual function. So it may affects attention span, alertness, and learning in both infants and adolescents.
Glossitis
Koilonychia (Spooning of the nails)
Stage I
. Iron depletion: This occurs when tissue stores are decreased without a change in hematocrit or serum iron levels. This stage may be detected by low serum ferritin measurements.serum ferritin, an iron-storage protein, provides a relatively accurate estimate of body iron stores in the absence of inflammatory disease.
Stage II
Iron-deficient erythropoiesis:This occurs when iron stores are completely depleted.
serum iron level drops
total iron binding capacity(serum transferrin) increases,
without a change in the hematocrit.
Stage III
Iron-deficiency anemia: As the deficiency progresses, the red blood cells (RBCs) become smaller than normal (microcytosis ), and their hemoglobin content decreases (hypochromia), increased red cell distribution width (RDW) and free erythrocyte protoporphyrins (FEP) accumulate(increase).The red cell distribution width (RDW) is a mathematical description of the variation in RBC sizes; a high RDW indicates greater variation in RBC size.
• LABORATORY FINDINGS
• Serum ferritin: The level of serum ferritin reflects the level of body iron stores; it is specific and sensitive. Normal ferritin levels, however, can exist in iron deficiency when bacterial or parasitic infection, malignancy or chronic inflammatory conditions co-exist because ferritin is an acute-phase reactant and its synthesis increases in acute or chronic infection or inflammation.2. Serum iron and iron saturation percentage(total iron binding capacity): It has the following limitations:
• • Wide normal variations (age, sex, laboratory methodology)
• • Time consuming
• • Subject to error from iron ingestion
• • Diurnal variation
• • Falls in mild or transient infection.
3. Hemoglobin: Hemoglobin is below the acceptable level for age .
4. Red cell indices: Lower than normal MCV, MCH and MCHC for age.
The RDW is high (>14.5%) in iron deficiency and normal in thalassemia (<13%).• 5. Free erythrocyte protoporphyrin (FEP): The incorporation of iron into protoporphyrin represents the ultimate stage in the biosynthetic pathway of heme. Failure of iron supply will result in an accumulation of free protoporphyrin not incorporated into heme synthesis and the release of erythrocytes into the circulation with high free erythrocyte protoporphyrin (FEP) levels.
• In both iron deficiency and lead poisoning, the FEP level is elevated,but it is much higher in lead poisoning than in iron deficiency. The FEP is normal in α- and β-thalassemia minor. FEP elevation occurs as soon as the body stores of iron are depleted, before microcytic anemia develops.
6. Blood smear: Red cells are hypochromic and microcytic with anisocytosis and poikilocytosis, generally occurring only when hemoglobin level falls below 10 g/dl.
Anisocytosis: Variation in size
Poikilocytosis: Variation in shape
• 7. Reticulocyte count: The reticulocyte count is usually normal but, in severe iron deficiency anemia associated with bleeding, a reticulocyte count of 3–4% may occur.
• 8.In about ⅓ of cases, occult blood can be detected in the stool. Negative guaiac tests for occult bleeding may occur if bleeding is intermittent; for this reason, occult bleeding should be tested for at least five occasions when gastrointestinal bleeding is suspected.
• Differential Diagnosis
• 1. Hemoglobinopathies : thalassemia (α and β)• β-thalassemia trait,
• The RBC count often is elevated above normal; while in iron deficiency, the RBC count usually decreases.
• The red cell distribution width is normal in patients with thalassemia but high in those with iron deficiency.
• β-Thalassemia trait characterized by elevated levels of hemoglobin A2 and/or increased fetal hemoglobin concentration.
• Normal (serum iron, total iron-binding capacity (transferrin), and ferritin) .
• α-Thalassemia trait is a diagnosis of exclusion except during the newborn period, when infants with α-thalassemia trait have 3–10% hemoglobin Barts (γ4) .
2. Lead poisoning: Disorders of heme synthesis caused by a chemical e.g Lead : and iron-deficiency anemia both are associated with elevations of FEP.
• Coarse basophilic stippling of the RBCs often is prominent.
• Elevated blood lead, and urinary coproporphyrin levels are seen.
representing aggregated ribosomes and
caused by ineffective heme formation3. Chronic infections or other inflammatory states:The anemia of chronic disease (ACD) and infection usually is normocytic, although occasionally it may be slightly microcytic . In contrast to iron-deficiency anemia, in these inflammatory conditions
• Serum iron level and iron-binding capacity (transferrin) are reduced
• Serum ferritin levels are normal or elevated (ferritin is an acute phase reactant).
• Serum transferrin receptor levels(STfR) is increased in instances of hyperplasia of erythroid precursors such as iron-deficiency anemia and thalassemia. It is unaffected by infection and inflammation.. It is therefore of great value in distinguishing iron deficiency from the anemia of chronic disease and in identifying iron deficiency in the presence of chronic inflammation or infection. It can be measured by a sensitive enzyme-linked immunosorbent assay (ELISA) technique
4. Sideroblastic anemias
• 5. Copper deficiency• Prevention
• Nutritional Counseling• 1. Maintain breast feeding for at least 6 months.
• 2. Use an iron-fortified (6–12 mg/L) infant formula until 1 year of age (formula is preferred to whole cow’s milk).
• Restrict milk to 1 pint/day.
• Avoid cow’s milk until after the first year of age because of the poor bio-availability of iron in cow’s milk and because the protein in cow’s milk can cause occult gastrointestinal bleeding.
• 3. Use iron-fortified cereal from 6 months–1 year.
• 4. soy-based formula should be used when iron-deficiency is due to hypersensitivity to cow’s milk.
• 5. Provide supplemental iron for low birth weight infants:
• • Infants 1.5–2.0 kg: 2 mg/kg/day supplemental iron
• • Infants 1.0–1.5 kg: 3 mg/kg/day supplemental iron
• • Infants <1 kg : 4 mg/kg/day supplemental iron.
• 6. Facilitators of iron absorption such as vitamin C-rich foods (citrus, tomatoes and potatoes), meat, fish and poultry should be included in the diet and inhibitors of iron absorption such as tea, phosphate and phytates common in vegetarian diets should be eliminated.
• TREATMENT
• Oral Iron Medication
• The goal of therapy for iron deficiency is both correction of the hemoglobin level and replenishment of body iron stores.
Product: Ferrous iron (e.g., ferrous sulfate, ferrous gluconate, ferrous ascorbate, ferrous lactate, ferrous succinate, ferrous fumarate, or ferrous glycine sulfate) is effective.
• The amount of elemental iron is
• 33% in ferrous fumarate
• 20% in ferrous sulfate
• 12% in ferrous gluconate
• One problem encountered with administration of oral iron to young children is that liquid FeSO4has an unpleasant taste.
• Problems with constipation can be minimized by increasing water and fiber intake.
• For some children, abdominal discomfort can be minimized by administering iron with food.
Dose: The therapeutic dose should be calculated in terms of elemental iron; A daily total dose of 4–6 mg/kg of elemental iron in 3 divided doses .
Duration: 10-12 weeks
TIME AFTER IRON ADMINISTRATIONRESPONSE
12–24 hour
Replacement of intracellular iron enzymes;
So decreased irritability and increased appetite
36–48 hour
Initial bone marrow response; erythroid hyperplasia
48–72 hour
Reticulocytosis, peaking at 5–7 days
4–30 days
Increase in hemoglobin level
(hemoglobin rises on average by 0.25–0.4 g/dl/day or hematocrit rises 1%/day during first 7–10 days, thereafter, hemoglobin rises slower: 0.1–0.15 g/dl/day)
1–3 months
Repletion of stores
• Response:
• 5. Failure to respond to oral iron: The following reasons should be considered:
• • Poor compliance – failure or irregular administration of oral iron; administration can be verified by change in stool color to gray-black or by testing stool for iron.
• • Inadequate iron dose
• • Ineffective iron preparation
• • Insufficient duration
• • Persistent or unrecognized blood loss
• • Incorrect diagnosis – thalassemia, sideroblastic anemia
• • Coexistent disease that interferes with absorption or utilization of iron (e.g., chronic inflammation, inflammatory bowel disease, malignant disease, hepatic or renal disease, concomitant deficiencies [vitamin B12, folic acid, thyroid, associated lead poisoning])
• • Impaired gastrointestinal absorption due to high gastric pH (e.g., antacids,histamine-2 blockers, gastric acid pump inhibitors).
• Parenteral iron Therapy
• A parenteral iron preparation (iron dextran) is an effective form of iron when given in a properly calculated dose.• Anaphylaxis is an occasional complication of iron dextran .
• Indications
• 1. Noncompliance or poor tolerance of oral iron.
• 2. Severe bowel disease (e.g., inflammatory bowel disease)
• 3. Rapid replacement of iron stores is needed.
4. Iron deficiency in heart failure.
Blood Transfusion
A packed red cell transfusion should be given in
• Severe anemia requiring correction more rapidly than is possible with oral iron or parenteral iron ,and when
• Signs of cardiac dysfunction are present and the hemoglobin level is 4 g/dl or less.
Packed RBCs should be administered slowly (2–3 mL/kg) of packed cells (furosemide also may be administered as a diuretic).